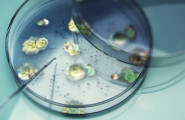

MKK-Energieberater – Ihr Spezialist für Schimmelanalyse und gesundes Wohnen
Seit über einem Jahrzehnt steht Jörg Beyreiß mit seinem Unternehmen MKK-Energieberater für Kompetenz, Zuverlässigkeit und nachhaltige Beratung – hauptsächlich im Main-Kinzig-Kreis und Umgebung, aber auf Wunsch auch bundesweit.
Als erfahrener Energieberater und Schimmelpilzsachverständiger verbindet er technisches Know-how mit einem klaren Ziel: Wohnräume zu schaffen, in denen sich Menschen dauerhaft wohlfühlen.
Ob Energieeffizienz, Immobilienbewertung oder Schimmelberatung – jeder Auftrag wird mit höchster Sorgfalt und fachlicher Präzision ausgeführt.
Besonders die Schimmelberatung bildet einen zentralen Schwerpunkt, denn sie vereint bauliche Sicherheit, Raumgesundheit und langfristige Werterhaltung Ihrer Immobilie.
Ursachen erkennen – Schimmel verstehen
Schimmel entsteht dort, wo Feuchtigkeit und Temperatur auf ungünstige Weise zusammentreffen – etwa an kalten Wänden, hinter Möbeln oder an Wärmebrücken.
Häufig spielen auch falsches Lüftungsverhalten oder bauliche Mängel eine Rolle.
Durch eine professionelle Ursachenanalyse findet MKK-Energieberater heraus, was genau hinter der Schimmelbildung steckt.
Mit modernen Messverfahren und jahrzehntelanger Erfahrung werden die Zusammenhänge zwischen Bauphysik, Raumklima und Feuchtigkeitsverteilung sichtbar gemacht – die Grundlage für eine gezielte und dauerhafte Sanierung.
Nachhaltig handeln – Sanieren und vorbeugen
Ist die Ursache erkannt, steht die Lösung im Mittelpunkt. MKK-Energieberater entwickelt individuelle Sanierungskonzepte, die nicht nur den vorhandenen Schimmel beseitigen, sondern auch künftige Schäden verhindern.
Dabei kommen Maßnahmen wie bauliche Optimierungen, die Beseitigung von Wärmebrücken und Empfehlungen zum richtigen Lüften und Heizen zum Einsatz.
Auf Wunsch werden auch energieeffiziente Systeme – etwa Infrarotheizungen – integriert, die zur Reduzierung von Feuchtigkeit beitragen.
Das Ergebnis: ein dauerhaft gesundes, trockenes und behagliches Raumklima – im Main-Kinzig-Kreis und darüber hinaus.
Sicher wohnen – mit professioneller Schimmelberatung
Schimmel in Innenräumen ist nicht nur unschön, sondern kann auch ernsthafte gesundheitliche Folgen haben.
Deshalb bietet MKK-Energieberater eine fachgerechte Schimmelpilzanalyse und persönliche Beratung, die Ursachen aufdeckt und gezielte Maßnahmen ermöglicht.
Mit einem klaren Blick für Details und viel Erfahrung begleitet Jörg Beyreiß Sie von der ersten Analyse bis zur erfolgreichen Prävention – hauptsächlich im Main-Kinzig-Kreis und Umgebung, aber auf Wunsch auch bundesweit.
Vertrauen Sie auf kompetente Beratung, transparente Kommunikation und nachhaltige Ergebnisse – für ein Zuhause, das Sie schützt und in dem Sie sich rundum wohlfühlen können.
Wie Schimmel entsteht – die häufigsten Ursachen im Überblick
In meiner täglichen Arbeit als Energieberater und Schimmelpilzsachverständiger sehe ich immer wieder ähnliche Muster bei der Entstehung von Schimmel: Statistisch gesehen liegt in rund 60 % der Fälle die Ursache in baulichen Mängeln, wie Wärmebrücken, schlechter Dämmung oder Baufeuchte. Etwa 30 % entfallen auf eine Kombination aus Baumängeln und falschem Lüften/Heizen, und nur in etwa 10 % der Fälle ist allein falsches Nutzerverhalten der Auslöser.
Die Quelle finden Sie bei: Inventer
Diese Zahlen zeigen deutlich, dass sich Schimmel nicht nur durch falsches Lüften oder seltenes Heizen erklärt, sondern in der Mehrheit der Fälle tiefer liegende bauliche Probleme zugrunde liegen. Genau deshalb setze ich bei jeder Schimmelanalyse nicht nur auf eine oberflächliche Begutachtung, sondern auf eine fundierte Bau- und Raumklimaanalyse. So erkenne ich Wärmebrücken, Feuchtigkeitsquellen oder Isolationsschwächen – und kann Ihnen Lösungen anbieten, die nachhaltig wirken und nicht nur Symptome bekämpfen. Für mich heißt gesundes Wohnen: Ursachen erkennen, bevor sich Schäden wiederholen.
| Ursache | Prozentuale Verteilung |
Typische Beispiele |
|---|---|---|
| Bauliche Mängel | 60 % |
Wärmebrücken, schlechte Dämmung, Bauschäden |
| Kombination Baumängel + falsches Lüften | 30 % |
Feuchte Luft trifft Kältebrücke, Kondensation |
| Falsches Lüften & Heizen allein | 10 % |
Zu seltenes Stoßlüften, unzureichendes Heizen |

Teilen Sie Ihre Erfahrungen